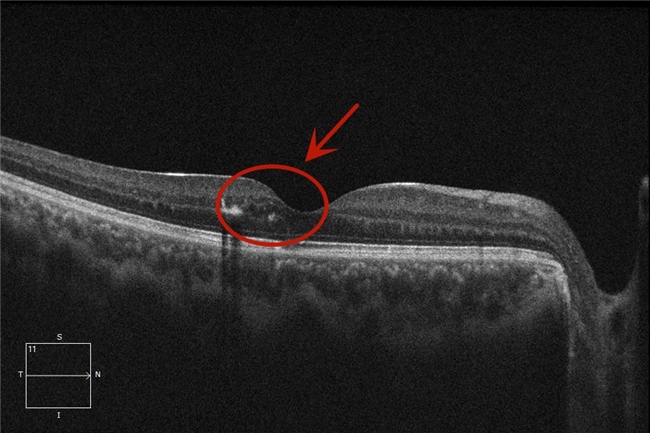

近日,天津普瑞眼科医院眼底病专科为一名患有“黄斑中心凹旁渗出性血管异常复合体(PEVAC)”的17岁在校学生小宇(化名),进行了玻璃体腔抗VEGF药物注射术。
年仅17岁的小宇,近两周出现右眼视力下降,于外院诊断为“黄斑变性”,但由于种种原因一直未进行系统治疗。为了寻求进一步诊治,在家长的带领下来到天津普瑞眼科医院眼底病专科就诊。
普瑞眼科眼底病专家团队经过会诊,发现其右眼视力仅为0.4并无法矫正提高,而左眼视力为1.0,经询问病史并进行光学相干断层扫描(OCT)、眼底荧光血管造影等检查,发现小宇的右眼出现了黄斑水肿。通常情况下,这个年龄的青少年,PEVAC的可能性较大,这种疾病对多数治疗手段缺乏敏感性,但如果不及时干预,将对其视力造成不可逆的影响,家长十分焦急,病情也非常棘手。

(术前黄斑水肿)
经过仔细分析,天津普瑞眼科医院李岩院长与眼底病专科李刚主任结合患者眼底病情,考虑PEVAC的诊断基本成立。鉴于病灶紧邻视力最敏锐的黄斑中心凹,传统激光治疗风险较高,可能对神经纤维层和视细胞造成损伤。经过审慎评估,为其制定了玻璃体腔抗VEGF药物注射方案,并进行了个性化的药物选择和治疗。
术后第一周复查结果显示,视力已从术前的0.4提升至0.8,黄斑水肿得以平复,小宇自觉右眼视力有了较大程度的提升,目前仍在随诊过程中。
(术后黄斑水肿消退)
天津普瑞眼科医院致力于通过构建疑难眼病专家会诊平台,持续为各类复杂眼病患者提供更高水平、更个体化的诊疗服务,用专业与责任守护每一位患者的视觉健康。
天津普瑞眼科医院眼底病专科,由眼科界技术过硬的专家团队组成。拥有美国Alcon玻切机、VisuaL532s眼底激光治疗系统、Hitachi彩色多普勒超声系统、A/B型眼科高频超声系统、Ubm超声生物显微镜、Optos超广角眼底成像系统、卡尔蔡司眼前节YAG激光系统、卡尔蔡司VISUCAM视网膜脉络膜联合造影系统、卡尔蔡司HD9000型血流OCT系统、卡尔蔡司Master700扫频源光学生物测量系统、Oculus眼前节分析系统等设备。能有效诊断各种常见及复杂的眼底病。在激光治疗眼底病、玻璃体切割治疗复杂视网膜脱离等领域积累了丰富的临场经验,并在眼科光学及声学生物测量方面实现了多模式影像诊断。
